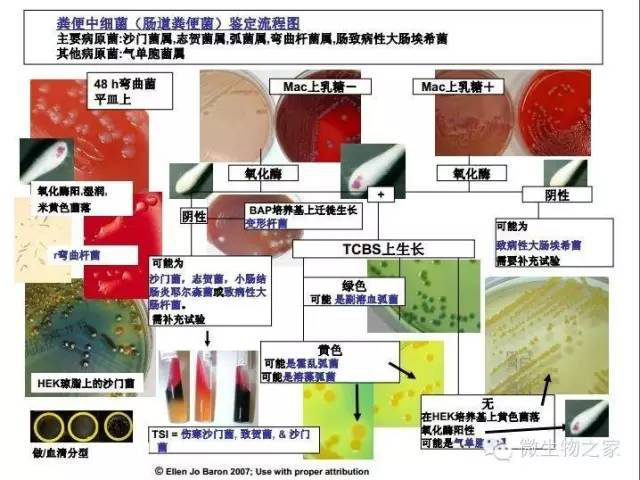

肠道标本的检验
-
1
-
2 虚拟仿真
上一节
下一节



目录